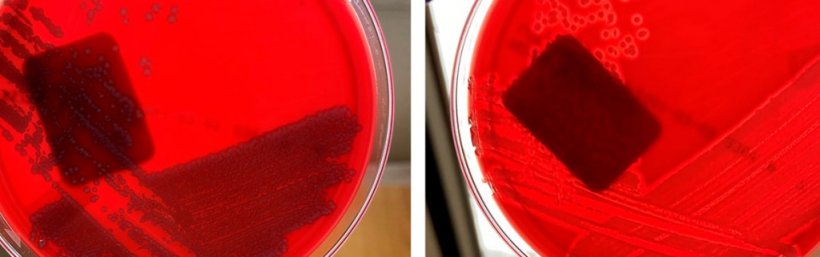
E. coli n&atilde;o hemol&iacute;tica (esquerda) e&nbsp;E. coli hemol&iacute;tica (direita)

Testes disponíveis
Cultivo bacteriano

- Isolamento de organismos vivos
- Tipo de amostra: fezes, conteúdo intestinal.
- Prós:
- As bactérias são fáceis de crescer em 1 dia
- Fácil de fazer em qualquer laboratório (mesmo interno).
- Custo relativamente baixo.
- Contras:
- Algumas E. coli formam parte da flora intestinal normal.
- Os suínos tem várias E. coli ao mesmo tempo.
-
Se os suínos forem previamente tratados com antibióticos, isso pode prevenir o crescimento bacteriano.
Susceptibilidade antimicrobiana (antibiograma)
- Teste in vitro: capacidade de um organismo vivo de crescer sob concentrações específicas de diferentes antimicrobianos.
- Tipo de amostra: fezes, conteúdo intestinal.
- Prós:
- Identificação de suscetibilidade ou resistência de cepas específicas a antimicrobianos comuns.
- Identificação de tendências de resistência antimicrobiana.
- Contras:
- Requer um isolado bacteriano.
- Os testes in vitro podem diferir ligeiramente dos resultados in vivo.
- Alguns antimicrobianos específicos podem não ser incluídos ou exigir testes especiais separados.
- Custo moderado.
Histopatologia
- Avalia a presença de lesões de tecido (dano) que podem confirmar a presença de doença. Às vezes, a presença de organismos também pode ser detectada diretamente (bactérias e parasitas) ou indiretamente (vírus) usando colorações especiais adicionais.
- Tipo de amostra: tecidos.
- Prós:
- Associa adesão bacteriana com dano intestinal.
- Nenhuma coloração especial é necessária.
- Contras:
- Os tecidos intestinais precisam de fixação com formalina dentro de 15 minutos após a morte do animal. O tecido intestinal se decompõe rapidamente.
- A doença pode ser segmentar, portanto, várias amostras intestinais devem ser enviadas.
Genotipagem
- Técnica de PCR (reação em cadeia da polimerase), que detecta a presença de uma sequência específica de ácidos nucléicos (DNA) associada a genes de virulência conhecidos.
- Prós:
- Realizado por PCR; fácil de fazer.
- Ajuda a identificar a patogenicidade detectando a presença de genes (não necessariamente expressão gênica) associados a fatores de virulência.
- Genes de toxinas: EAST1, LT, STa, STb, Stx1, Stx2, Stx2e.
- Genes de Pilus: F18, F41, K88 (F4), K99 (F5), 987P (F6).
- Genes de Adesinas: AIDA, EAEA, PAA.
- Facilita a seleção adequada da vacina (combinando pili correto).
Genes de E. coli detectados mediante genotipificação por PCR e por sua função.
| Gene | Tipo | Descrição |
|---|---|---|
| EAST1 | Toxina |
A toxina intestinal se liga ao mesmo receptor e estimula a mesma via secretora que a Sta (a causa da diarreia não está bem estabelecida) |
| LT | Toxina | Toxina Intestinal que estimula a secreção intestinal |
| STa | Toxina | Toxina intestinal que estimula a secreção intestinal, principalmente em leitões (diminui a absorção de água e eletrólitos) |
| STb | Toxina | Toxina intestinal que estimula uma diarreia secretora principalmente suínos mais velhos (aumenta a secreção dos enterócitos) |
| Stx1 | Toxina |
Toxicidade intestinal pode ser encontrada em cepas patogênicas e não patogênicas. |
| Stx2 | Toxina |
Toxicidade intestinal pode ser encontrada em cepas patogênicas e não patogênicas. |
| Stx2e | Toxina |
Toxina sistêmica que induz dano vascular e doença do edema. |
| F18 (F107) | Adesina | Pili (fimbria) usado para aderir que está presente após os 20 dias de idade e comumente associado a diarreia pós-desmame e doença do edema. |
| F41 | Adesina | Pili (fimbria) usada para adesão principalmente em recém nascidos. |
| K88 (F4) | Adesina | Pili (fimbria) usada para permitir adesão em animais de todas as idades. |
| K99 (F5) | Adesina | Pili (fimbria) usada para adesão principalmente em neonatos. |
| 987P (F6) | Adesina | Pili (fimbria) usada para adesão principalmente em neonatos. |
| AIDA | Adesina |
Adesina envolvido na adesão não fimbrial difusa, mais comumente encontrada em conjunto com F18. |
| EAE | Adesina | Adesina não fimbrial, que contribui para lesões de "attaching-and-effacing". |
| PAA | Adesina |
Adesina não fimbrial essencial para a ocorrência de lesões de "attaching-and-effacing". |
- Contras:
- Requer isolamento bacteriano.
- Os suínos podem ter mais de uma linhagem ao mesmo tempo, então devemos esperar ter isolado a linhagem correta..
- Preço moderado, mas geralmente apenas uma cepa isolada é testada.
Interpretação de resultados
Cultivo bacteriano

- A interpretação da hemólise depende da idade dos animais:
- Pré desmame: E. coli. não hemolítica
- Pós desmame: E. coli hemolítica.
- Pureza:
- Crescimento puro: altamente sugestivo de que contribui para a doença.
- Crescimento misto: valor questionável.
- Quantidade:
- Alta: altamente sugestivo de que está contribuindo com a doença.
- Moderado: interpretação variável.
- Baixo: valor questionável (poderia ser um contaminante).
- Sem crescimento: Animal possivelmente tratado previamente com antibióticos para o agente, sem contribuição significativa.
Susceptibilidade antimicrobiana (antibiograma):
- Suscetível: Possível boa escolha para tratamento se o antimicrobiano puder atingir o tecido-alvo.
- Resistente: um antimicrobiano diferente deve ser selecionado.
- CIM: Se a CIM (concentração inibitória mínima) for realizada, deve-se garantir que o antimicrobiano selecionado atinja o valor da CIM indicado no órgão-alvo.
Histopatologia
- Positivo: Forte associação como causa se for capaz de demonstrar lesões intestinais com E. coli aderindo as células epiteliais.
- Negativo: Sem lesões intestinais.
Genotipagem
-
A genotipagem é muito valiosa para identificar se a E. coli isolada contém algum dos fatores de virulência que dariam suporte ao isolado como patógeno.
Coleta de amostrar para análises
Suínos com diarreia (qualquer idade) :
- Colete swabs retais de 2 ou mais animais com diarreia, não tratados com antibióticos e envie-os para cultura bacteriana, antibiograma e genotipagem.
- Eutanásia 1-3 leitões com diarreia que não receberam tratamento. Colete imediatamente 3 amostras de intestino de cada leitão e coloque-as em solução de formaldeído. Colete amostras frescas de intestino para enviá-las refrigeradas para cultura bacteriológica, antibiograma e genotipagem.